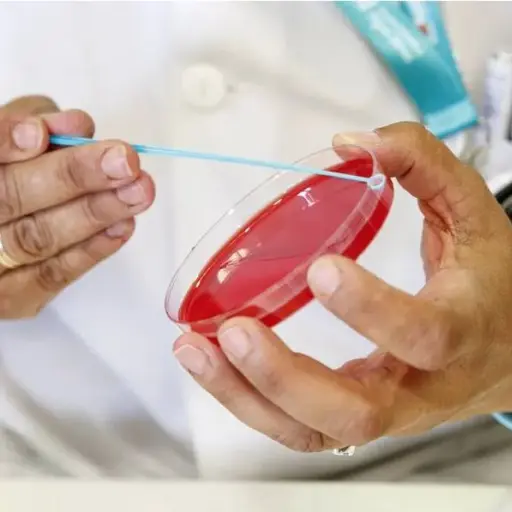
Personal técnico de laboratorio prepara unas muestras para analizar por posible sarampión. ,Ilustrativa de archivo: EFE

Brote
Nacionales
Salud emite nuevas recomendaciones por brote de sarampión
- por Eliseo de León
- 07:49 AM, Ene 10
Internacionales
China endurece confinamiento por nuevo brote de Covid-19
- por Oliver Paniagua
- 10:58 AM, Abr 03
En Portada
Temas
×

¿Activar notificaciones?
Recibe las últimas novedades directamente en tu dispositivo.